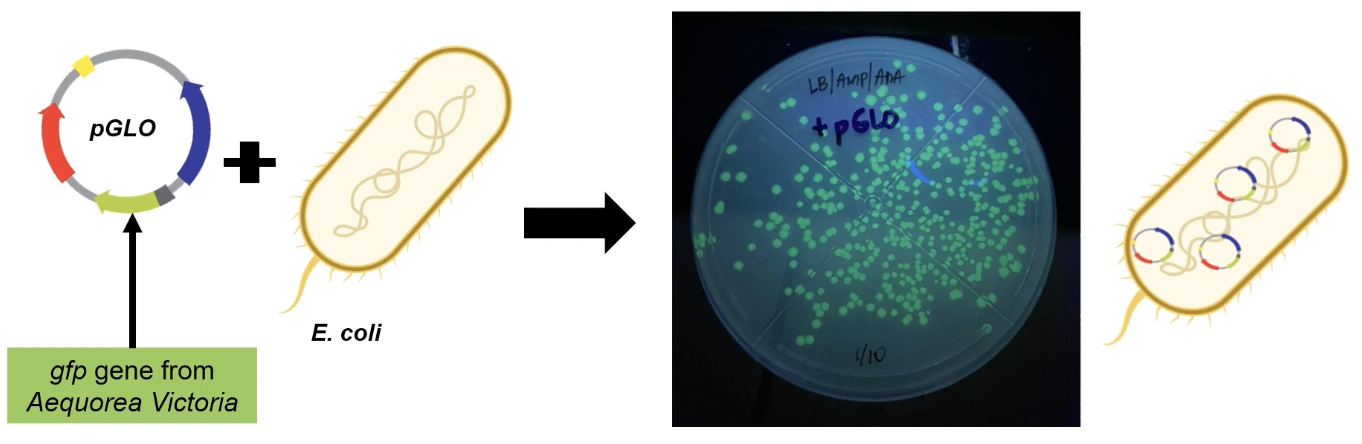

LBBBI16 Bacterial Transformation | Transformation of Escherichia coli HB101 K12 with pGLO

gfp gene from Aequorea Victorea + E. coli
Glowing bacterial coloniesmeans the gene was translated into protein hence the transformation process was successful.Escherichia coli - gram negative and are anaerobic. Inhabits human and animal intestinal tracts.
If Escherichia coli is found in other parts of the body, it would most likely result in diseases like Urinary Tract Infections.
Escherichia coli HB101 is a hybrid of strain K12 and strain B.
K12 strains are used for routine cloning
Strain B is used for protein expression analysis
E. coli HB101 has 13 mutations making it useful for plasmid propagation or making copies of plasmid and horizontal gene transfer
recA13 is responsible for homologous genetic recombination and repair.
hsdS20 is a restriction genotype that prevents the production of endonucleases.
HB101 is susceptible to B-lactam antibiotics such as ampicillin.
The four genetic characteristics are: 1) able to replicate; 2) Store information; 3) express information; 4) allow variation (mutation)
DNA → RNA → Protein: The flow of Central Dogma
Genetic material is a hereditary molecule
DNA has a double helix structure with chains running in an anti-parallel direction.

Sense Strand goes from 5’ to 3’
- Sense strand has the same base sequence as RNA transcript
- Sense strand is also called Coding strand or Non-template strand
Antisense strand goes from 3’ to 5’
Antisense strand is also called Template or Non-coding strand.
Antisense strand is used as the template strand in the transcription process
resulting mRNA has the same direction and sequence as the sense strand

Main components of a gene includes the promoter, RNA-coding sequence, and the terminator.
- Promoter is where the transcription is initiated
- RNA-coding sequence is the coding region
- Terminator marks the end of the transcription
- Upstream is the term used when it goes towards the 5’ end
- Downstream is a term used when it goes towards the 3’ end
ORGANIZATION OF A BACTERIAL PROMOTER SEQUENCE

- It is in the promoter region that the RNA polymerase bind
SELECTION OF A PROMOTER

The selection of a promoter is crucial as it will determine the rate at which the mRNA is synthesized
Strong promoter produces more proteins
Synthesis of mRNA can be controlled by adding regulatory elements
Inducible gene is a gene that is normally off but switches on upon the addition of a regulatory element
Repressible gene is a gene that is normally on but goes off upon the addition of a regulatory element
Gene regulation is a complex process which the promoter is directly involved.
\

HORIZONTAL GENE TRANSFER

- Horizontal gene transfer is the transfer of genetic material from one bacterium to another from the same generation.
- The three types of gene transfer are bacterial transformation, bacterial transduction, and bacterial conjugation
- Bacterial transduction involves bacteriophages
- Bacterial conjugation involves cell wall to cell wall transfer
TRANSFORMATION [Competent Cell]

Transformation may be done through DNA, fragments of DNA, or through plasmids
Before the transformation, the bacterial cells have to be prepared and have to be Competent cells
Competent cells mean they are capable of DNA uptake
For DNA fragments to be competent cells, they have to undergo bacterial chromosomal configuration by recombination which means they will be integrated with the chromosomal DNA of the bacterium.
The fragments will be degraded by the nucleases if the integration of DNA fragments during transformation did not occur.
The plasmid of the DNA may be inserted in a plasmid vector

The five Plasmid classifications are the R, F, Col, Degradative, and Virulence plasmids.
In the process of transformation and conjugation, plasmids are used as vectors or carriers to transform a gene into a bacterium.
Plasmids are extrachromosomal DNA that is double-stranded and helical and covalently closed circular.
Plasmids may undergo supercoiling as well.
Plasmids are rarely existing in the domain of eukarya.
Plasmids are smaller and are dispensable for the cell.
Genetic markers for plasmids are antibiotic resistant.
R plasmids are resistance plasmids that carry genes that are resistant to one or more anti-bacterial agents such as antibiotics
F plasmids are fertility plasmids that promotes conjugal transfer of plasmids
Col plasmids are colicins plasmid which is a plasmid that can kill bacteria
Degradative plasmids enable the host to degrade unusual molecules
Virulence plasmids give pathogenicity on the host
PLASMID STRUCTURE

The origin of replication, antibiotic resistance gene, multiple cloning sites, insert, promoter region, a selectable marker, and primer binding site are what make up the plasmid structure.
- Origin of replication initiates the replication
- antibiotic resistance gene allows the selection of plasmid-containing cells
- multiple cloning sites is where the gene of interest is inserted
- insert
- promoter region
- selectable marker can be an additional antibiotic resistance gene
- primer binding site
When you want to insert a gene into the plasmid, you have to treat both the gene interest and the plasmid interest with the same restriction enzymes that would produce sticky ends.
GENE CLONING


The plasmid used in the activity is called the pGLO plasmid.
The pGLO plasmid is composed of the origin of replication, ampicillin resistance gene, the AraC gene, and the GFP gene that is regulated by the PBAD promoter.
GFP gene is used as a reporter gene to know if the transformation is successful or not.
Aequorea Victoria is the origin of the GFP gene.
The GFP absorbs the short wavelength high energy photons from the UV light, then a longer wavelength with lower energy green photons is mixed with it.

The pGLO will be transformed in E.coli HB101.
Competence refers to the ability of a cell to take up DNA and be transformed.
E coli is NOT naturally competent
To induce competence in E. coli, calcium chloride treatment can be done through electroporation.
Electroporation uses electric shock that makes the cell membrane permeable to DNA.
Process of Competency in the Activity to be performed:
- grow cells in a medium for 2 hours
- harvest the cells using centrifugation. The supernatant will be discarded
- For chemical competency, the cells will be treated with a calcium chloride solution.
- For electric competency, the cells will be washed and resuspended with ionized sterile water.
- Aliquoting and storage at -70 Deg. Celsius
TRANSFORMATION METHODS
- The two most common transformation methods are the heat shock method and the electroporation method.
- In
heat shockmethod, the mixture of the competent cells and the recombinant DNA molecule is incubated in ice for 30 minutes and then transferred at 42 degrees celsius for 30 to 45 seconds, and is immediately returned to the ice. - In electroporation, the mixture of the competent cells and the recombinant DNA molecule is electrically shocked instead of applying heat.
- Then after the application of the methods, the growth medium are added to the mixture and are allowed to grow for 37 degrees celsius.
- It will then be plated in a medium containing antibiotics